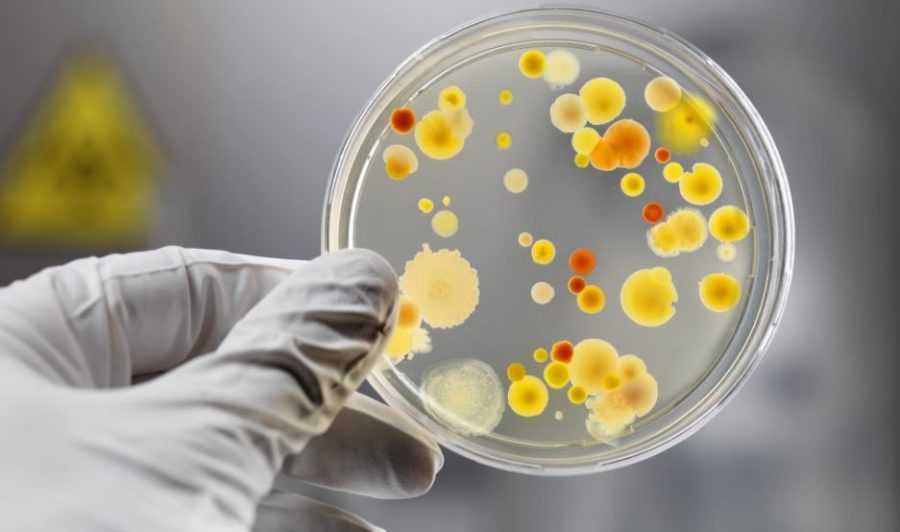

Профилактика микоплазмоза у кошек
Предотвратить заражение кошки микоплазмозом можно. Для этих целей необходимо придерживаться профилактических мер. Прежде всего, нужно:
- Своевременно вакцинировать любимца. Различные инфекции провоцируют ослабление защитных сил организма. Поэтому риск развития микоплазмоза на фоне плохого иммунитета очень высок.
- Предотвращать контакт животного с бездомными или заведомо больными сородичами.
- Создавать правильный уход. Сюда входит не только подбор сбалансированного питания, но и моцион кошки.
Важно следить за тем, чтобы посуда для кормления и воды всегда была чистой. Не стоит забывать и о регулярных профилактических осмотрах у ветеринарного врача. Необходимо консультироваться с врачом по поводу обогащения рациона витаминно-минеральными комплексами
Необходимо консультироваться с врачом по поводу обогащения рациона витаминно-минеральными комплексами.
Любые изменения в состоянии здоровья – повод внепланового посетить специалиста. Лучше начать лечение заболевания на ранних стадиях, чем в дальнейшем заниматься терапией серьезной патологии.
Автор и ведущий рубрики: Ветеринарный врач Санаев Игорь Викторович
В связи с большим потоком поступающих вопросов, бесплатные ветеринарные консультации временно приостановлены.
Симптомы заболевания у грызунов. Как распознать недуг?
Выявить причину заболевания вашей декоративной крысы довольно-таки просто. Как утверждают ветеринары, достаточно сделать качественную диагностику, и будут четко выявлены причины и симптомы, которые трудно можно спутать с проявлением других болезней.
Данное заболевание может поражать как молодых, так и старых особей, повреждая верхние дыхательные пути.
Как только ослабевает организм,развивается воспаление, которое локализуется в верхних дыхательных путях, постепенно инфекция опускается вниз, переходя в бронхит, развитие протекает стремительно, т.к. у крыс обмен веществ, проходит очень стремительно.
Часто встречающиеся симптомы микоплазмоза у крыс ничем не отличаются от инфекций, проявляющихся у других домашних животных и проявляются рядом симптомов, таких как:
- Ринит.
- Неровное (сбитое) дыхание.
- Физическая слабость.
- Отвращение к еде.
- Чихание.
Болезнь инфицированного грызуна может прогрессировать с каждым днем все больше, и если вовремя не обратить на это внимания, это может привести к поражению легких.
Диагностика микоплазмоза у крыс

Очень важно распознать заболевание микоплазмоз на начальных этапах, пока состояние больного грызуна можно проконтролировать и принять необходимые меры предосторожности
Поэтому стоит обращать внимание на симптомы инфекции как можно раньше, назначить соответствующие анализы, поставить точный диагноз и приступить к безотложной терапии
Клинические признаки
Само заболевание имеет ярко выраженные признаки и симптомы, поэтому спутать его с чем-либо другим невозможно. Первые дни заболевшей крысы отличаются частыми хрипами, животное перестает принимать пищу, отмечается вялость и апатия, шерсть теряет свою эластичность, она становится более тусклой и неухоженной.
При обследовании выявляется, что на легких у декоративной крысы появляются изменения, пузырьки и нарывы покрывают большую часть легких, что ведет к развитию пневмонии, а также к нарушению флоры матки. Глаза и нос начинают выделять жидкость в виде слизи, что подтверждает факт нарушения дыхательной системы.
Развитие инфекционного заболевания других животных очень похоже по развитию с заболеванием у крыс. Нарушение дыхательных путей, отравление сильными химическими веществами вызывают одинаковые симптомы:
- кашель и чихание;
- забитое носовое дыхание;
- носовое кровотечение;
- одышка.
Перед началом лечения микоплазмоза у крыс, желательно точно поставить диагноз и выявить точные причины болезни. При необходимости заменить корм, перестелить подстилку, избавиться от резких запахов (не использовать вблизи клетки бытовую химию, духи, дезодоранты), по необходимости поменять место нахождения клетки. Проверить крысу на наличие паразитов в организме (вшей, блох).
Если при резкой смене условий обитания у крысы снизится защитная реакция организма, проявится стресс, ухудшится самочувствие – знайте, это не заболевание, а реакция на новые условия обитания.
Стадии заболевания и их краткое описание
Скрытые симптомы болезни грызунов на первых порах не так заметны, декоративные крысы ведут себя естественно — проявляют активность, у них присутствует аппетит. Хотя нарушение слизистой, хрипы, одышка легких в организме уже проявляются. Координация заметно ухудшена, неестественные позы являют собой выраженную картину болезни. На начальном этапе заболевания грызуны ведут себя неактивно, отмечается потеря аппетита. В термальной стадии присутствуют такие признаки микоплазмоза у крыс: температура тела снижается, прослеживается замедленные реакции, вялость, апатия.
| Скрытая стадия | Начальная стадия | Термальная стадия |
| Симптомы отсутствуют | Чихание, выделения из носовых ходов | Пониженная температура, одышка, снижение активности |
Что собой представляет микоплазмоз и откуда берётся
Микоплазмоз представляет собой инфекционную патологию, возбудители которой паразитируют на красных кровяных тельцах, вызывая нарушение их функционирования. Микроорганизмы, деятельность которых является причиной микоплазмоза, относят к условно-патогенным. Микоплазмы могут на протяжении всей жизни существовать в организме носителя и никак не влиять на его самочувствие. Разновидностей этих микроорганизмов несколько, но вызвать патологию у кошек могут только две из них — Mycoplasma felis и Mycoplasma gatae. Микоплазмы присутствуют в теле большинства животных и, никак не влияя на состояние конкретной кошки, могут стать причиной заражения другого животного. Бактерии присутствуют также в окружающей среде, но, не отличаясь живучестью, быстро погибают. Поэтому заразиться извне практически невозможно. Микроорганизмы передаются несколькими путями:
- алиментарным, когда проникновение бактерий происходит через рот;
- половым;
- воздушно-капельным;
- контактным.
Причины возникновения микоплазмоза
К болезни приводит активация деятельности микоплазм, вызванная определёнными условиями. Происходит это, как правило, при недостаточном уровне иммунитета у животного. В группе риска находятся ослабленные, имеющие хронические патологии кошки, а также молодые особи до 2 лет. В период внутриутробного развития или в момент прохождения через родовые пути матери заразиться могут также детёныши. Начиная стремительно размножаться, бактерии, не имея клеточной оболочки, прикрепляются к клеткам организма носителя и начинают поглощать питательные вещества. Кроме того, выделяя в процессе своей жизнедеятельности вредные вещества, они вызывают интоксикацию. Животное слабеет, у него начинают проявляться другие симптомы.

Заразиться микоплазмозом может новорождённый котёнок
Существует ли опасность для человека
Микоплазмы, поражающие кошку, не опасны для человека. Но всё же большинство специалистов советуют соблюдать правила гигиены при контакте с больным животным, особенно когда болезнь находится в стадии обострения. Желательно в этот период ограждать от контактов с питомцем маленьких детей и людей с ослабленным иммунитетом.
Диагностика микоплазмоза
Диагностирование микоплазмоза проводится лабораторными методами исследования. Поскольку характерные симптомы микоплазмоза отсутствуют, а сам микроорганизм насколько мал, что неразличим под микроскопом, применяется ряд альтернативных методик.
Назначается анализ посева на питательные среды. Этот культуральный метод имеет высокую точность и позволяет определить наличие микоплазм в организме. Но так как их различные виды есть практически у всех людей, назначаются дополнительные анализы, которые устанавливают вид микоплазмы и ее воздействие на организм.
Диагностика микоплазмоза включает такие исследования: метод полимеразноцепной реакции, метод иммунофлуоресценции, а также иммуноферментный анализ для исследования специфических антител.
Лечение Микоплазмоза у крыс
Нет лекарства или вакцины от Микоплазмоза. Однако инфекцию и симптомы можно подавить с помощью антибиотиков на ранних стадиях заболевания, но, скорее всего, они перерастут в хроническое состояние, требующее периодического или даже постоянного лечения. Это заболевание прогрессивно обостряется, в конечном итоге вызывая уплотнение легких и абсцессы в легких, что приводит к смерти.

Белых крыс широко используют в лабораториях
Некоторые антибиотики, доказавшие свою эффективность против микоплазм, – это “Тетрациклин”, “Тилозин”, “Гентамицин”, “Амикацин”, “Хлорамфеникол”, “Доксициклин” и “Энрофлоксацин” (“Байтрил”). Дозы следующие:
- “Тетрациклин” перорально от 5 до 10 мг на 500 г веса три раза в день в течение не менее 14 дней.
- “Тилозин” перорально по 4,5 мг на 500 г веса два раза в день или 66 мг на литр воды в течение 14-30 дней.
- “Гентамицин” (лучше всего использовать в сочетании с цефадроксилом) в дозе 1-2 мг на 500 г вводят два раза в день в течение 7-14 дней.
- “Амикацин” в дозе 5 мг на 500 г веса вводят два раза в день в течение 7-14 дней.
- “Хлорамфеникол” в дозе от 15 до 25 мг на 500 г вводят два раза в день в течение 7-14 дней.
- “Доксициклин” перорально по 2,5 мг на 500 г два раза в день в течение 14-30 дней.
- “Энрофлоксацин” (“Байтрил”) перорально по 5 мг на 500 г два раза в день в течение 14-30 дней.
“Байтрил” и “Доксициклин” также очень хорошо работают в комбинации.

На поздних стадиях заболевания кортикостероиды, такие как “Преднизон” (вводимый в дополнение к антибиотикам), могут помочь уменьшить воспаление. Уменьшая воспаление в инфицированных легких, крыса может легче дышать, что приводит к менее частым приступам удушья, что позволяет продлевает жизнь крысы.
Еще один препарат, полезный при тяжелых случаях пневмонии, – это “Аминофиллин”. Этот препарат расслабляет и расширяет бронхи, помогая крысе дышать легче. Дозировка: от 2,5 до 5 мг на 500 г перорально или вводится два или три раза в день.
Также во время лечения необходимо соблюдать следующие рекомендации:
- Регулярно проводите уборку в жилище грызуна.
- Дезинфицируйте клетку питомца специальными средствами каждый день.
- Постоянно проветривайте комнату.
- Контролируйте оптимальную температуру помещения.
- Убирайте испражнения питомца как можно чаще.
Самым эффективным методом введения лекарств признан инъекционный метод. Однако многие владельцы не умеют делать уколы. Для подкожного метода необходимо ввести иглу в складку шеи. Внутримышечные инъекции делаются в задние лапы. Для инъекций лучше использовать исулиновые шприцы. Также для выполнения манипуляции вам понадобится помощь другого человека, который будет держать животное
Важно помнить, что после приема антибиотиков крысе нужно будет дать пробиотики
Лечение микоплазмоза в ВЦ «РосВет»
При поступлении животного в нашу ветеринарную клинику мы проводим все необходимое обследование, включая и лабораторные исследования. При постановке точного диагноза начинается лечение, оно длительное, проходит с применением антибиотиков, к которым чувствительны микоплазмы: левомицетин, тетрациклин, доксициклин. Сульфаниламиды и бета-лактамы не эффективны, к ним микроорганизмы устойчивы.
Улучшение условий содержания, кормления и повышение иммунитета – обязательное условие в борьбе с микоплазмами. Собак и кошек переводят в чистое, сухое помещение с обогревом (если зима), без сквозняков и достаточной вентиляцией. Диета – полноценное кормление, сбалансированное по питательным веществам, витаминам, микроэлементам.
Если у Вашего питомца обнаружились перечисленные симптомы, есть признаки простуды или поражения мочеполовой системы – не медлите! Позвоните в ВЦ «РосВет» по телефону: +7 (495) 256-11-11, круглосуточно. Запишитесь на прием к ветеринарному врачу и доставьте животное на обследование. Запущенный микоплазмоз вылечить очень трудно, поэтому обращение в клинику должно быть уже при первых признаках недомогания питомца.
МИКОПЛАЗМОЗ У БЕРЕМЕННЫХ ЖЕНЩИН
В период беременности микоплазмоз обостряется и часто вызывает осложнения. Случаи «выкидышей» и замерших беременностей во многих ситуациях вызваны именно обострением микоплазмоза. Даже в том случае, когда плацента помешала инфекции проникнуть в плод, воспалительный процесс переходит на плодные оболочки, вызывая их разрывание, отхождение околоплодных вод и преждевременные роды. Более того, плод также получает эту инфекцию от матери во время родов.
В период планирования беременности женщина должна в обязательно порядке сдать все анализы и пройти курс лечения в том случае, если у нее диагностирован микоплазмоз. Этим она защитит не только своего ребенка, но и себя, так как помимо всего прочего это заболевание приводит к развитию сильнейших инфекционных процессов в матке после родов или кесарева сечения.
Описание возбудителя микоплазмоза
Инфекционное заболевание, контагиозного типа, провоцирует изменения в функционировании различных систем организма. Микоплазмоз приводит к проблемам в работе мочевыделительной и дыхательной системы, провоцирует развитие конъюнктивитов и воспалительных процессов в суставах.
В некоторых случаях, кошка может быть носителем микоплазмы, но симптомы заболевания у нее будут отсутствовать. В связи с этим, диагностика микоплазмоза значительно осложнена.
Проблемы в области форменных элементов крови зачастую связаны с микоплазмозом у кошек. У домашних питомцев диагностируют гемолитическую анемию аутоиммунного типа. Микроскопические паразитарные организмы, активно поражают эритроциты, вызывая специфический ответ иммунной системы. В результате это приводит к тому, что собственные защитные клетки воспринимают эритроциты как чужеродные, начиная атаковать их.
В ветеринарии изучены всего три вида микоплазм, чаще всего диагностируемых у домашних животных:
- М. haemofelis
- М. haemominutum
- М. turicensis
Микоплазма haemofelis самый крупный из вышеперечисленных кровопаразитарных микроорганизмов и в подавляющем большинстве случаев становиться причиной патологических процессов в организме домашних кошек. В группу риска по развитию микоплазмоза входят кошки со слабой иммунной защитой – молодые и пожилые животные, а также те, которые находятся в состоянии стресса или перенесшие серьезные заболевания.
Доказана и связь между развитием микоплазмоза у кошек с наличие вирусного иммунодефицита и вирусной лейкемии у кошек. Истинного пути передачи микоплазмоза выявить не удалось, но предположительно потенциальным звеном считается кошачья блоха.
От больного животного к здоровому микоплазмоз может передаваться при тесном контакте (например, половая связь или драка). Драки с сородичами, сопровождающиеся серьезными укусами до крови, царапинами и другими повреждениями.
Предположительно, микоплазмозом способны заражать инфицированные кошки, вынашивающие потомство. При прохождении через родовые пути, малыши заражаются микоплазмозом и могут даже погибнуть, так как их иммунная система ослаблена.
Симптомы микоплазмоза
Первые признаки болезни проявляются через несколько дней после заражения. Главный симптом, позволяющий заподозрить инфекцию – покраснение конъюнктивы. Возбудители поражают слизистую оболочку, провоцируют появление выделений из глаз (могут быть прозрачными, с желтым оттенком, гнойные).
При инфицировании могут проявляться и другие клинические признаки:
- повышение температуры тела;
- вялость, слабость;
- кашель, чихание;
- снижение аппетита, полный отказ от еды.
Если кошка здорова, нет отягощающих заболеваний, проявления микоплазмоза исчезнут без лечения и назначения антибиотиков. Признаки могут сохраняться в течение 1-1.5 недель, затем состояние нормализуется.
При снижении иммунитета часто присоединяется вторичная инфекция, поражаются внутренние органы. В этом случае к клиническим проявлениям добавятся специфические симптомы:
- поражения мочеполовой сферы (цистит, простатит, недержание мочи и проч.);
- расстройства пищеварительного характера (рвота, диарея);
- артрит и прочие проблемы с опорно-двигательным аппаратом, хромота;
- подкожные абсцессы, ранки на коже, выпадение шерсти;
- серьезное поражение половой системы приводит к выкидышу, рождению мертвых котят.
Профилактика
Профилактика ООИ проводится на самом высоком уровне, чтобы предотвратить распространение заболеваний по территории государства. В комплекс первичных профилактических мероприятий входит:
- временная изоляция зараженного с дальнейшей госпитализацией;
- постановка диагноза, созыв консилиума;
- сбор анамнеза;
- оказание больному первой помощи;
- забор материала для лабораторного исследования;
- выявление контактных лиц, их регистрация;
- временная изоляция контактных лиц до момента исключения их заражения;
- проведение текущей и заключительной дезинфекции.
В зависимости от типа инфекции, профилактические мероприятия могут различаться:
- Чума. В природных очагах распространения проводятся наблюдения за численностью грызунов, их обследование и дератизация. В прилегающих районах проводится вакцинация населения сухой живой вакциной подкожно или накожно.
- Холера. Профилактика включает в себя также работу с очагами распространения инфекции. Проводится выявление больных, их изоляция, а также изоляция всех лиц, контактирующих с зараженным. Осуществляется госпитализация всех подозрительных больных с кишечными инфекциями, проводится дезинфекция. К тому же требуется контроль на данной территории за качеством воды и продуктов питания. Если существует реальная угроза, вводится карантин. При угрозе распространения проводится иммунизация населения.
- Сибирская язва. Осуществляется выявление больных животных с назначением карантина, дезинфекция меховой одежды при подозрении на заражение, проведение иммунизации по эпидемическим показателям.
- Оспа. Методы профилактики заключаются в вакцинации всех детей, начиная с 2-х лет, с последующей ревакцинацией. Эта мера практически исключает возникновение оспы.
- Желтая лихорадка. Также осуществляется вакцинация населения. Детям показано введение вакцины с 9-месячного возраста.
Итак, особо опасные инфекции — это смертельные инфекции, которые обладают высокой степенью заразности
За кратчайшие сроки они способны поразить большую часть населению, поэтому крайне важно соблюдать все меры предосторожности в работе с зараженными животными и птицами, а также своевременно проводить вакцинацию
Также в разделе
| Диссеминированная гонорейная инфекция Гонококки проникают в кровяное русло, вероятно, в большинстве случаев гонореи, чему способствует деструкция слизистой оболочки уретры и шеечного канала. Однако… | |
| Гонорея у детей В связи с увеличением заболеваемости взрослых заметно участились случаи заболевания гонореей детей . Гонореей могут болеть мальчики и девочки. Однако… | |
|
Врожденный сифилис. Прогноз и профилактика врожденного сифилиса. Возможность передачи сифилитической инфекции потомству была установлена еще в конце XV в. во время эпидемии сифилиса в Западной Европе. Однако несколько… |
|
|
Диагностика и лечение инфекций, передающихся половым путем (ИППП) О проблеме: Венерические заболевания на сегодняшний день являются серьезной медико-социальной проблемой, особенно для лиц молодого и юного возраста. И вот… |
|
|
Урогенитальный трихомониаз. Этиология. Пути распространения трихомониаза. Симптомы трихомониаза. Профилактика трихомониаза. Трихомонадное поражение мочеполовых органов — широко распространенное инфекционное воспалительное заболевание, передаваемое половым путем. Этиология…. |
|
| Вторичный период сифилиса (Syphilis secundaria) Вторичный период сифилиса нередко начинается с продромальных явлений, которые возникают обычно за 7-10 дней до появления вторичных сифилидов. Чаще они… | |
| Сифилис внутренних органов (Lues visceralis) Являясь инфекцией всего организма, сифилис уже в ранних стадиях развития поражает многие внутренние органы и системы. При поздних формах сифилиса, в том числе… | |
| Поражение костей и суставов при сифилисе Заболевания костей при позднем сифилисе известны давно, еще в 1544 г. Виго сообщил об экзостозах и ночных болях в костях при сифилисе. Однако только благодаря… | |
| Генитальный герпес. Этиология. Симптомы генитального герпеса. Профилактика. Герпес является одной из самых распространенных вирусных инфекций человека и представляет собой серьезную медико-социальную проблему. Свыше 90% людей земного… | |
| Папилломавирусная инфекция урогенитального тракта. Этиология. Клиническая картина. Диагностика. Профилактика. В Международной классификации X пересмотра папилломавирусная инфекция урогенитального тракта выделена в раздел «других болезней, передающихся… |
Особенности возбудителя: чем опасна микоплазма
Микоплазмы — это очень мелкие микроорганизмы. По своим размерам они ближе всего стоят к вирусам, но так же, как и у бактерий, ДНК микоплазмы включает в себя нуклеиновые кислоты (ДНК и РНК). В настоящее время их можно рассматривать как переходную ступень от микроорганизмов к одноклеточным. Существует 15 видов микоплазм, способных жить в человеческом организме, но возбудителями болезней являются только 3 вида: Mycoplasma hominis, Mycoplasma genitalium, Mycoplasma orale, Mycoplasma pneumoniae.
Микоплазмы не имеют клеточной стенки, ее функцию выполняет трехслойная клеточная мембрана. Ввиду того что клеточной стенки у микоплазм нет, они невосприимчивы к отдельным лекарственным препаратам, в том числе к пенициллинам, так как эти антибиотики воздействуют именно на данную структуру различных возбудителей.
Локализация микоплазм происходит не в ядре или цитоплазме клетки-хозяина, а на поверхности клеточных мембран, представляя собой процесс «слияния», благодаря которому микоплазмы не подвергаются фагоцитозу (нападению) и способны длительно и мирно сосуществовать до определенного момента. Снижение иммунитета, беременность и сопутствующие урогенитальные инфекции приводят к бурному росту этих микроорганизмов и развитию инфекционного поражения не только мочеполовой системы, но и дыхательных путей. Также микоплазма паразитирует на мембране сперматозоидов.
Симптомы микоплазмоза
В половине случаев заболевания микоплазмозом начало болезни проходит бессимптомно, или симптомы микоплазмоза незначительны. Признаки заражения могут проявляться примерно на3-5 недели после попадания микоплазмы в организм. При микоплазмозе у мужчин поражается уретра, семенные пузырьки, яички и их придатки, мочевой пузырь, парауретальные ходы, предстательная железа.
При поражении органов мочеполовой системы наблюдаются такие симптомы микоплазмоза как выделения из мочеиспускательного канала. Выделения имеют прозрачный цвет, часто сопутствующим признаком является боль при мочеиспускании, может развиваться простатит. Поражение придатка яичка чаще всего вызывает тянущую боль в паху, промежности и мошонке. Придаток увеличивается, наблюдается покраснения кожи мошонки.
Поздняя диагностика микоплазмоза из-за скрытых симптомов часто приводит к осложнениям. Это могут быть болезни мочевыводящей системы и предстательной железы. Некоторые ученые считают, что микоплазмоз у мужчин может вызывать бесплодие, но такие данные очень противоречивы.
Микоплазмоз у женщин поражает в основном верхние отделы генитального тракта – цервикальный канал, фаллопиевы трубы. Попадают микробы в эти отделы преимущественно с мужской семенной жидкостью, сперматозоиды выступают в роли носителей уреаплазм. У женщин заболевание может вызывать вторичное бесплодие, то есть воспалительный процесс нарушает функцию образования яйцеклетки, а также препятствует ее нормальному продвижению.
Поражение мочеполовой системы микоплазмами характеризуется наличием разных клинических форм. Проявления могут быть как малосимптомными, так и острыми. Чаще всего преобладает хроническая форма заболевания с малосимптомным торпидным течением. Признаки и течение болезни мало чем отличаются от заболеваний такой же этиологии – гонореи, трихомониаза.
Иногда появляются симптомы похожие на эти болезни. Жжение и зуд наружных половых органов, кожные высыпания, боли в печени. Микоплазмоз у мужчин чаще обнаруживается болезненным мочеиспусканием и бесцветными выделениями. Признаками заражения у женщин могут быть межменструальные кровянистые или коричневые выделения. Человек, зараженный микоплазмами, склонен к простудным заболеваниям и другим инфекционным поражениям.
Лечение микоплазмоза у кошек
На основе полученных анализов ветеринаром могут формироваться основные этапы лечения. Глубокая диагностика может включать также анализы крови на выявление других возможных возбудителей, так как зачастую микоплазмоз возникает на фоне другого заболевания. Лечение микоплазмоза у кошек не простое, так как необходимо подбор индивидуальной схемы. Используются следующие комплексы:
- антибиотики – Доксицилин, Тетрациклин;
- общеукрепляющие препараты – Гамавит, Катазал;
- иммуномодулирующие средства – Трансфер Фактор и Иммунофан;
- гепатопротекторы – Карсил;
- противовоспалительные средства — Дексавет.
Также назначаются препараты для промывания глаз на основе лекарственных растений и дезинфицирующих растворов.




























